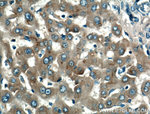
Apolipoprotein AI Antibody in Immunohistochemistry (Paraffin) (IHC (P))

Search
Proteintech
Apolipoprotein AI Polyclonal Antibody
{{$productOrderCtrl.translations['antibody.pdp.commerceCard.promotion.promotions']}}
{{$productOrderCtrl.translations['antibody.pdp.commerceCard.promotion.viewpromo']}}
{{$productOrderCtrl.translations['antibody.pdp.commerceCard.promotion.promocode']}}: {{promo.promoCode}} {{promo.promoTitle}} {{promo.promoDescription}}. {{$productOrderCtrl.translations['antibody.pdp.commerceCard.promotion.learnmore']}}
产品信息
14427-1-AP
种属反应
已发表种属
宿主/亚型
分类
类型
抗原
偶联物
形式
浓度
规格
纯化类型
保存液
内含物
保存条件
运输条件
产品详细信息
This antibody was generated against the C-terminal region of human ApoA1.
Immunogen sequence: RHFWQQDEP PQSPWDRVKD LATVYVDVLK DSGRDYVSQF EGSALGKQLN LKLLDNWDSV TSTFSKLREQ LGPVTQEFWD NLEKETEGLR QEMSKDLEEV KAKVQPYLDD FQKKWQEEME LYRQKVEPLR AELQEGARQK LHELQEKLSP LGEEMRDRAR AHVDALRTHL APYSDELRQR LAARLEALKE NGGARLAEYH AKATEHLSTL SEKAKPALED LRQGLLPVLE SFKVSFLSAL EEYTKKLNTQ (19-267 aa encoded by BC005380)
靶标信息
Apolipoprotein A-1 (apo A-1) in human plasma is a major protein component of high density lipoprotein (HDL). The molecular mass is 24 kDa. Apo A-1 is a cofactor for enzymes involved in the normal turnover of cholesterol and is produced in the liver. Plasma concentration is 270-380 mg/100 mL.
仅用于科研。不用于诊断过程。未经明确授权不得转售。
生物信息学
蛋白别名: 1-Sep; 2-Sep; Apo a; apo A-1; APO A1; APO I; Apo-AI; ApoAI; Apolipoprotein; Apolipoprotein A-I; Apolipoprotein A1; Apolipoprotein AI; epididymis secretory sperm binding protein; MGC102525; MGC117399; MGC124929; proapo-A-I protein; proapolipoprotein; Udpgt; Ugt1; Ugt1a7; unnamed protein product
基因别名: Alp-1; AMYLD3; apo(a); apo-AI; Apoa-1; apoA-I; APOA1; Brp-14; HPALP2; Ltw-1; Lvtw-1; Sep-1; Sep-2; Sep2
UniProt ID: (Human) P02647, (Mouse) Q00623
Entrez Gene ID: (Human) 335, (Mouse) 11806